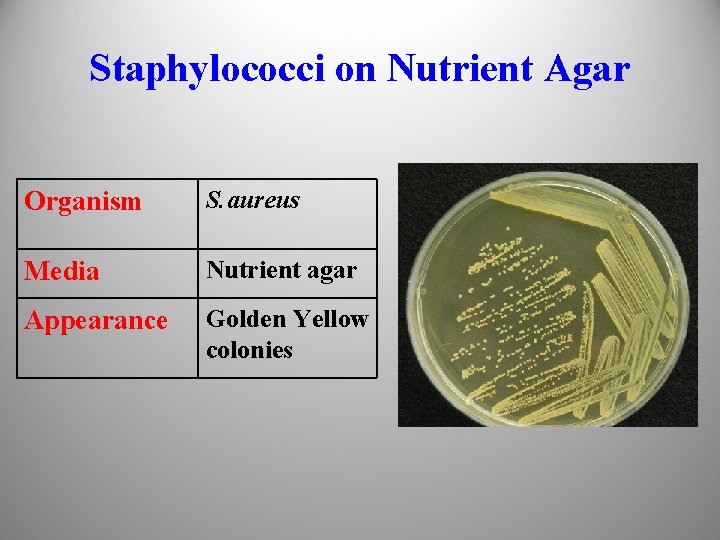
Staphylococci on Nutrient Agar Organism S. aureus Media Nutrient agar Appearance Golden Yellow colonies
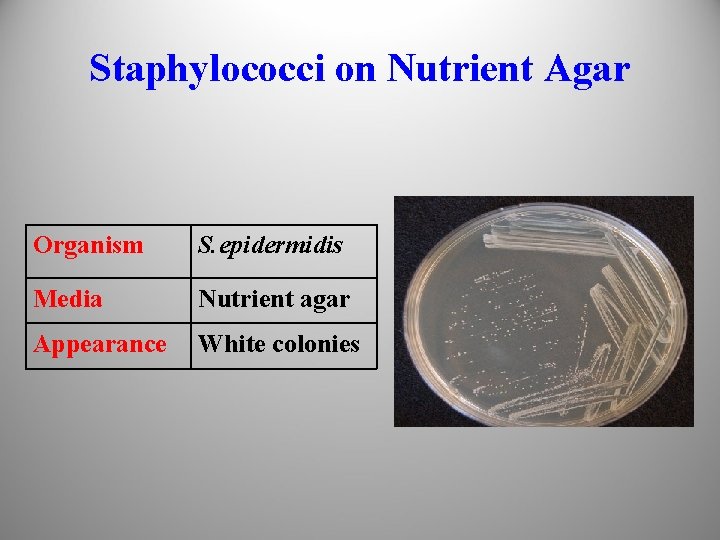
Staphylococci on Nutrient Agar Organism S. epidermidis Media Nutrient agar Appearance White colonies
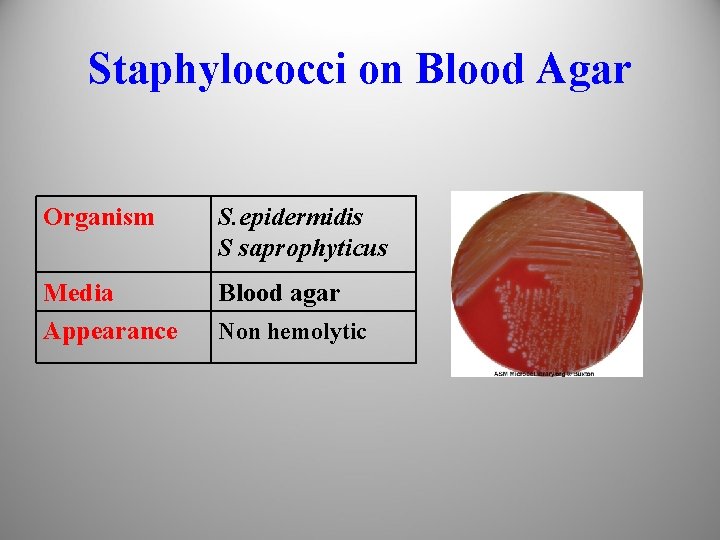
Staphylococci on Blood Agar Organism S. epidermidis S saprophyticus Media Appearance Blood agar Non
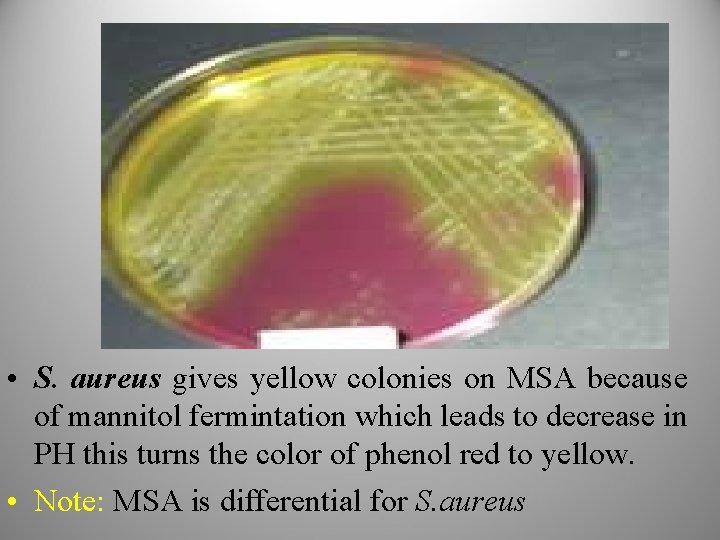
• S. aureus gives yellow colonies on MSA because of mannitol fermintation which
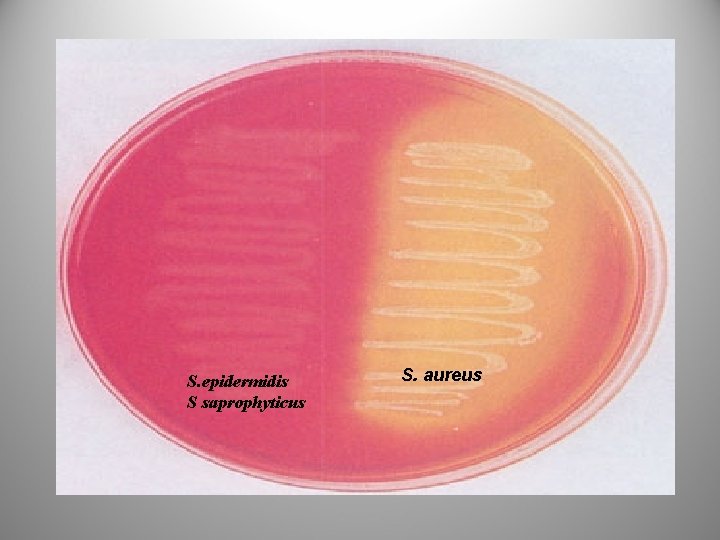
S. epidermidis S saprophyticus S. aureus
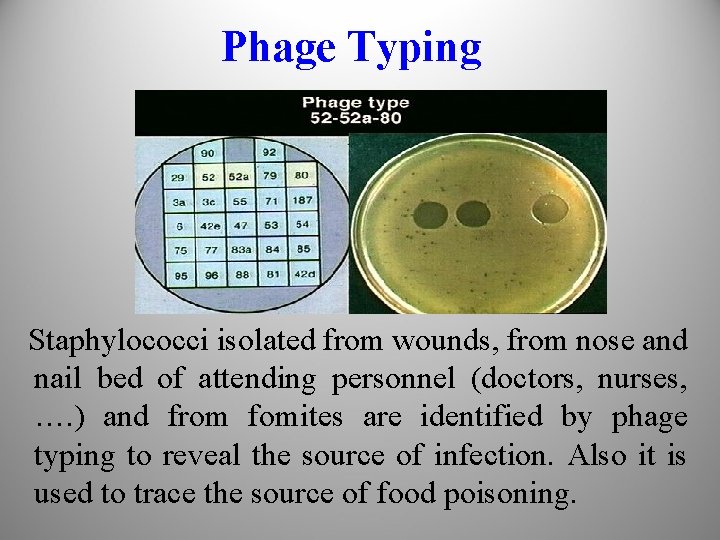
Phage Typing Staphylococci isolated from wounds, from nose and nail bed of attending personnel

PHT 313 Lab 1 Staphylococci Bacteria Grams Stain

PHT 313 Lab (1) Staphylococci

Bacteria Gram’s Stain Gram’s +ve Cocci Staphylococci Streptococci Micrococci Bacilli Corynbacterium Clostridum Bacillus Gram’s -ve Cocci Neisseria Bacilli Enterobacteriaceae Pseudomonas.

Staphylococci • Three mainly species that are human pathogens: • Staph. aureus • Staph. epidermidis • Staph. saprophyticus

Habitat: • S. aureus: – Nasal passages, skin, oral cavity and gastrointestinal tract. • S. epidermidis: – skin. • S. saprophyticus: – Rarely found in healthy humans.

Microscopic Morphology: • Gram positive cocci, arranged in grape like clusters, non-motile, nonspore forming.

Coagulase positive e. g. S. aureus According to Coagulase enzyme production Classification Coagulase negative e. g. S. epidermidis & S. saprophyticus Golden yellow colonies S. aureus According to Pigment production (endopigment) White colonies S. epidermidis Yellow colonies S. saprophyticus

Culture Characteristics • • Environment: Facultative anaerobe Temp. : 37 ° C PH: 7. 2 Media: – Nutrient agar (Simple medium). – Blood agar (Enriched medium). – Mannitol salt agar (Selective & diffrential medium).
Staphylococci on Nutrient Agar Organism S. aureus Media Nutrient agar Appearance Golden Yellow colonies
Staphylococci on Nutrient Agar Organism S. epidermidis Media Nutrient agar Appearance White colonies

Staphylococci on Blood Agar Organism S. aureus Media Blood agar Appearance Beta heamolysis (complete haemolysis)
Staphylococci on Blood Agar Organism S. epidermidis S saprophyticus Media Appearance Blood agar Non hemolytic

Mannitol Salt Agar (MSA) • • The name: Mannitol salt agar Appearance: Solid, opaque, pink. Type: Selective & diffrential medium Composition: Contains high conc. of salt (about 7. 5%). – Test sugar: mannitol. – p. H indicator: phenol red (red in alkaline, yellow in acidic p. H). • Sterilization: autoclave.

• S. aureus gives yellow colonies on MSA because of mannitol fermintation which leads to decrease in PH this turns the color of phenol red to yellow. • Note: MSA is differential for S. aureus
S. epidermidis S saprophyticus S. aureus

Deoxyribonuclease (DNase) Test: Principle: DNase enzyme DNA Insoluble In acid Nucleotides soluble In acid Procedure: 1. Inoculate DNase agar plate with the test organism. 2. Incubate the plate at 35 o. C for 24 hrs. 3. Flood the plate with 1 M HCl.

Results: • DNase activity is indicated by a clear zone around the growth after addition of Hcl Cloudiness in all the plate S. epidermidis Clear zone around the growth while the rest of the plate appears cloudy S. aureus

Biochemical Tests Catalase test: Differentiative test to separate Staphylococci and Micrococci which are catalase +ve from Sterptococci which are catalase –ve. Principle: H 2 O 2 Procedure: Catalase enzyme H 2 o + O 2 Air bubbles

Results: Positive test: Rapid appearance of gas bubbles. Catalase +ve Staphylococci or Micrococci Catalase –ve Streptococci

Coagulase Test: • Definitive test to differentiate between S. aureus & other species of staphylococci (coagulase-negative staphylococci “CONS”) e. g. S. epidermidis Principle: Fibrinogen Plasma Procedure: Coagulase enzyme Fibrin Visible Clot 1 2 3 Place at water bath at 37 o. C, observe formation of visible clot for up to 4 hrs.

Results: Positive test: Formation of visible clot. Coagulase -ve S. epidermidis Coagulase +ve S. aureus

Diseases • Due to invasion: • Toxin mediated – Local lesions of skin e. g. boils, carbauncles, abscesses. – Systemic infections e. g. septicemia, meningitis. – Food poisoning – Toxic shock syndrome – Scalded skin syndrome

Diagnosis 1. The specimen: • Swab from wounds, abscesses • Blood in case of septicemia • Urine in case of UTI • CSF in case of meningitis. 2. Direct examination : • Film is prepared and examined by gram stain.

3. Culture : S. aureus: • Nutrient agar: Golden yellow colonies • Blood agar: Beta hemolysis. • MSA: Yellow colonies (mannitol fermentation)

S. epidermidis: • Nutrient agar: White colonies • Blood agar: Non haemolytic • MSA: Non fermentative S. saprophyticus: • Nutrient agar: Yellow colonies • Blood agar: Non haemolytic • MSA: Non fermentative

4. Biochemical reactions: • Catalase test : positive • Coagulase test: positive in case of s. aureus

5 -Typing • Used for epidemiological purposes. – Phage typing. – Antibiogram. – Molecular typing (ribotyping or PCR).
Phage Typing Staphylococci isolated from wounds, from nose and nail bed of attending personnel (doctors, nurses, …. ) and from fomites are identified by phage typing to reveal the source of infection. Also it is used to trace the source of food poisoning.

Antibiogram • Helpful in tracing sources of staphylcoccal infections

Molecular typing (ribotyping or PCR) • Used to document the spread of epidemic disease-producing clones of S. aureus

- Slides: 31